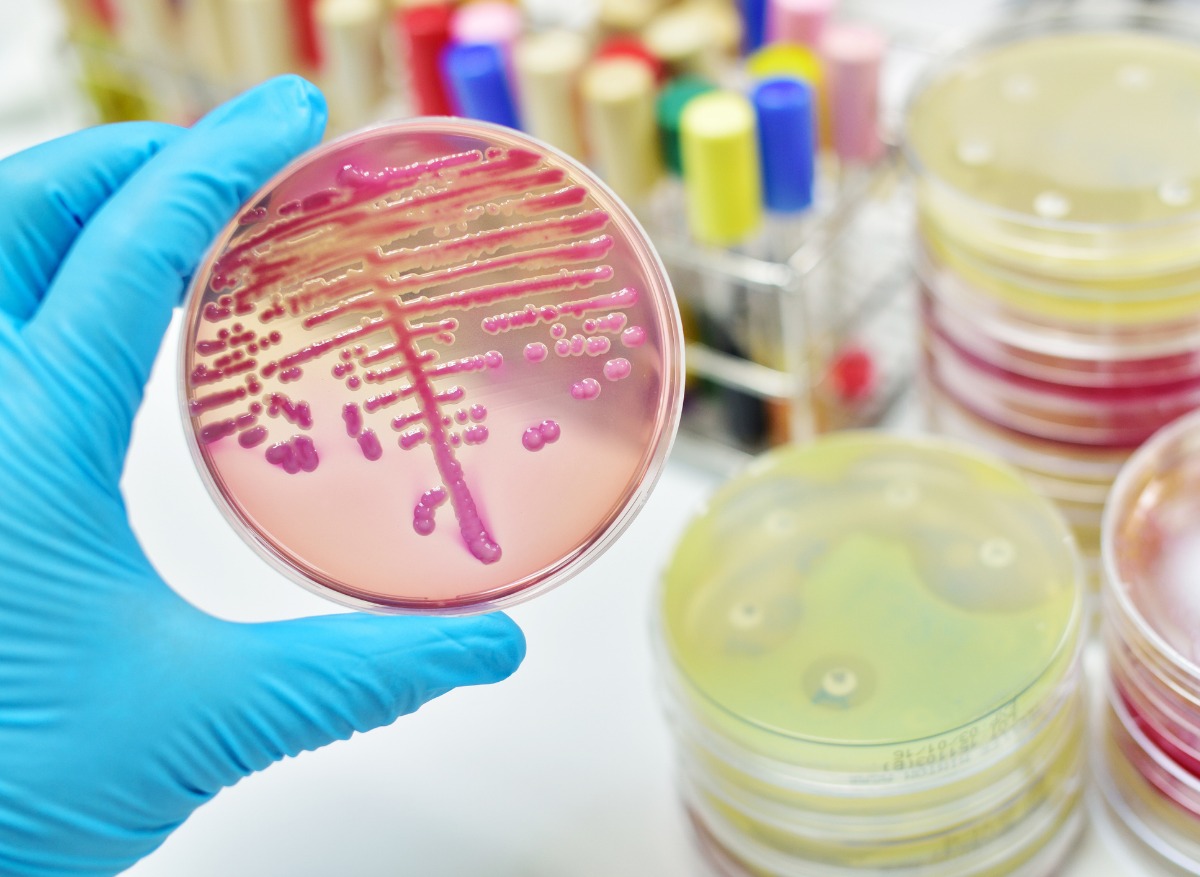

C’est un phénomène de plus en plus préoccupant pour les professionnels de santé du monde entier : la résistance aux antibiotiques. Le Centre européen de contrôle des maladies estime qu’il y a 25 000 décès par an en Europe dus aux bactéries résistantes. Ce type de germes se développe tout particulièrement dans les hôpitaux.
Pour comprendre ce phénomène, il faut d’abord analyser le fonctionnement des antibiotiques. Ils permettent de combatte une maladie due à des bactéries (par exemple une pneumonie, bronchite, otite, infection urinaire, ou encore une MST - maladie sexuellement transmissible). L’antibiotique va détruire la bactérie associée à la maladie, ainsi que d’autres au passage, surtout s’il est mal prescrit. Lorsque l'on prend trop d’antibiotiques, les seules bactéries qui ne sont pas détruites s’accommodent, s'adaptent et deviennent plus résistantes. On dit alors que le malade est porteur d’une population de germes résistants à un ou plusieurs antibiotiques.
La dangerosité des bactéries résistantes
Un Plan national pour préserver l’efficacité des antibiotiques a d’ailleurs été mis en place en France – d’où le credo "les antibiotiques, c’est pas automatique", mais la consommation d’antibiotiques reste trop élevée dans l’Hexagone. Le problème se pose surtout quand ce sont des bactéries comme le staphylocoque qui deviennent résistantes, car celles-ci sont particulièrement agressives et peu de traitements fonctionnent contre elles.
Voilà pourquoi l’Institut Pasteur lance l’alerte : en 2016, "près de 140 000 nouveaux cas d’infection à bactérie résistante ont été identifiés, alerte-t-il, ce qui représente 12% de toutes les infections bactériennes ayant nécessité une hospitalisation". Il précise que les infections urinaires, respiratoires et intra-abdominales représentent les 2/3 de ces hospitalisations, car elles concernent les 3 types de bactéries particulièrement résistantes : E. coli (résistant aux céphalosporines), le staphylocoque doré (résistant à la méthicilline (SARM)) et les bactéries pyocyaniques.
Quel coût entraîne la résistance aux antibiotiques ?
Une équipe de chercheurs de l'université de Versailles Saint-Quentin-en-Yvelines, de l'Inserm et de l'Institut Pasteur (Unité Mixte de Recherche 1181 Biostatistique, biomathématique, pharmacoépidémiologie et maladies infectieuses – B2PHI) a donc voulu savoir quel coût économique entraîne la résistance aux antibiotiques. Les scientifiques ont fait leurs estimations le plus précisément possible grâce au Système National des Données de Santé (SNDS), qui "inclut des informations de diagnostic systématiquement collectées lorsqu'un malade séjourne dans un hôpital français", détaille l’Institut Pasteur.
L’équipe de recherche a pu avoir des informations sur plus de 10 millions de patients hospitalisés pendant les années 2015 et 2016. Ainsi, elle a estimé le coût économique direct que représentent les infections à bactéries résistantes aux antibiotiques à 1100 € en moyenne par séjour hospitalier. Pour l’ensemble de la population, cela représenterait près de 290 millions d'euros. Un surcoût non négligeable, surtout quand on sait que 3,8 milliards d'économies sont attendus en 2019 sur le budget santé.